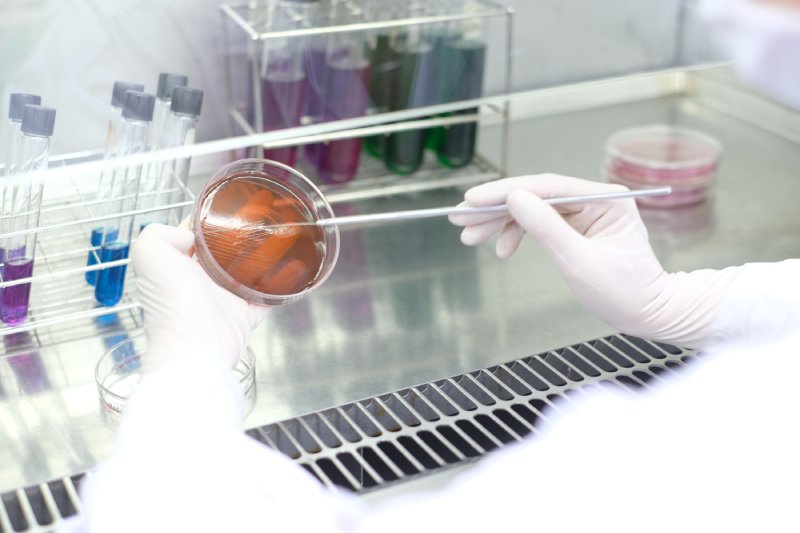
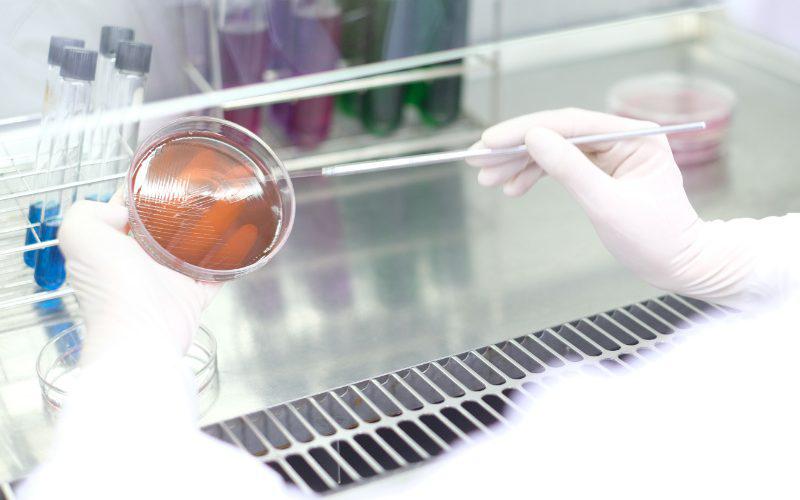

At Interthai Pharmaceuticals, we recognize that quality is the foundation of trust. Our Quality Control and Analytical Services are designed to guarantee that every product manufactured under our care meets the highest international standards of safety, efficacy, and consistency.
Our ISO/IEC 17025-accredited Quality Control Laboratory operates under PIC/S GMP guidelines and is equipped with advanced analytical instrumentation for testing raw materials, in-process samples, and finished products. From method development to validation, our experienced scientists ensure full regulatory compliance and seamless product release.
We implement a Laboratory Information Management System (LIMS) to optimize efficiency, traceability, and data integrity throughout the analytical process. Combined with our Enterprise Quality Management System (EQMS), Interthai maintains digitalized, fully documented processes that support transparency and reliability.